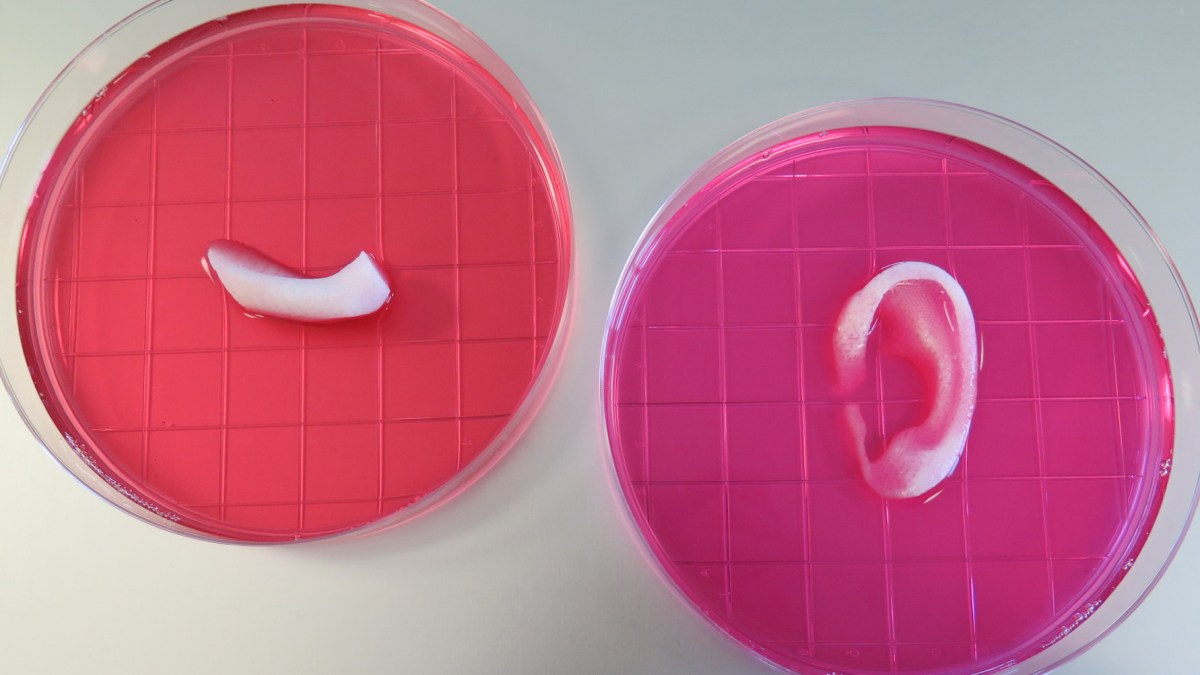

In the future, it’s possible no one will ever have to be on a donor list. Everyone will be on top, and the wait for a heart, liver, or pancreas will be as long as it takes to print it. Scientists at Wake Forest Baptist Medical Center have proven this kind of complex bioprinting is possible in their recent study.
“This novel tissue and organ printer is an important advance in our quest to make replacement tissue for patients,” said Anthony Atala, M.D., director of the Wake Forest Institute for Regenerative Medicine (WFIRM) and senior author on the study. “It can fabricate stable, human-scale tissue of any shape. With further development, this technology could potentially be used to print living tissue and organ structures for surgical implantation.”

For the first time, scientists have successfully produced functional pieces of human tissue made from living cells. The bioprinter was used to make ear, bone, and muscle structures made out of “biodegradable, plastic-like materials” and living cells.
Their biggest challenge in this 10-year-long piece of research was creating the right environment for the tissue to attach and grow without dying. The printed tissue would need to live long enough to attach to the host and develop. The researchers used a water-based bio-ink to hold the cells and created micro-channels, which allowed oxygen and nutrients from the body to diffuse into the printed tissue. This system helped keep the tissue alive while also promoting the growth of blood vessels.
The researchers have only tested the integration of these structures on rodents, but their results seem promising. They’ve so far successfully implanted a printed ear, skull bone, and muscle tissue in rats. The researchers say further studies will be looking at long-term outcomes with these implants.
***
Photo Credit: Image courtesy of Wake Forest Baptist Medical Center
Natalie has been writing professionally for about 6 years. After graduating from Ithaca College with a degree in Feature Writing, she snagged a job at PCMag.com where she had the opportunity to review all the latest consumer gadgets. Since then she has become a writer for hire, freelancing for various websites. In her spare time, you may find her riding her motorcycle, reading YA novels, hiking, or playing video games. Follow her on Twitter: @nat_schumaker